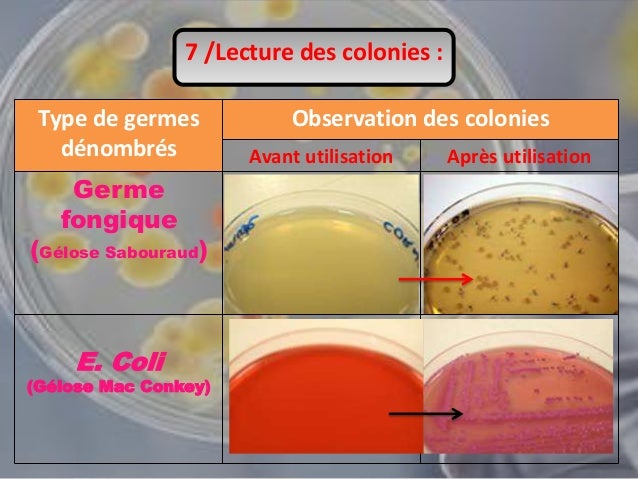
les techniques de controle microbiologique des medicaments

Launch the photos app from your dock. You will see the option of delete slide.
How To Delete A Slideshow In Photos Mac, Hold mouse over photo show, where at the side or over ? Anyway, how do you do it. If you can find the location of the picture, you can follow the steps below to find and delete it.

Tap the trash button , then tap delete photo. Click preview > preferences in the menu bar, then head to the “images” tab. Use the 7 photo editing features to edit your pictures like enhance, rotate, crop, filters, remove red eyes, etc. After selecting, you will be presented with four options:
Caderno de obstetricia digitado If my photo stream isn�t turned on, delete photos from the photos app instead.
Click preview > preferences in the menu bar, then head to the “images” tab. Click themes from the left column, and you can see the image name under background. Search the image name in file explorer. How to change your slideshow music in memories in the photos app. Including text, shapes, tables, charts, photos, and videos. Beside “when opening files” check “open groups of files in the same window.”.

Pharmacology of therapeutic gases and inhalational anesthetics, Use duplicate file finder to scan and delete duplicate photos. Click select and move the cursor to pick the photos you want (multiple photos). Tap the trash button , then tap delete photo. Tap �select� button and then select the photos and videos and then tap �recycle bin� icon. Beside “when opening files” check “open groups of files in the.

Caderno de obstetricia digitado, Click image on the top menu bar of your mac screen > tap show edit tools. How to remove animation from powerpoint step 1. How to change your slideshow music in memories in the photos app. Forward, recycle bin to delete, add to (to create or add to an existing button) and, the cancel option which unselects the selected photos..

Buy MAGIX Photo Manager Deluxe 2015 on SOFTWARELOAD, Delete photos on mac in one click. Then the editing features in photos will show up. Tap the trash button , then tap delete photo. Moreover, you can click the. The duplicate finder tool on the left sidebar is able to scan all duplicated photos on your mac.
les techniques de controle microbiologique des medicaments, Just like customizing the theme of your memories slideshow, you can also change up the music! Duplicating a slide makes a copy of it that includes any changes you made to the layout and content of the original slide. Whatever on the mac or windows desktop will display on the tv screen. Anyway, how do you do it. You will.

Ginnie Mae�s Housing Finance Reform Overview, Find the target image and delete it. The it states to click red x lower right hand corner. Launch the photos app from your dock. Give your slideshow a name and click ok. The duplicate finder tool on the left sidebar is able to scan all duplicated photos on your mac.

Tabla Comparativa, Use duplicate file finder to scan and delete duplicate photos. Anyway, how do you do it. Right click on it in the sidebar and select delete. You can also add text for your photo slideshow by moving to the text tab. Add or delete slides in keynote on mac.

Comparison of windows linux and mac os, Speciality level out of ten: After scanning, check boxes next to the unwanted photos and hit the clean button to remove them from your hard drives. I wish you could just highlight it and delete. Find the target image and delete it. Beside “when opening files” check “open groups of files in the same window.”.

E+H Proof testing level instruments, Find the target image and delete it. I wish you could just highlight it and delete. Click on the transition tab to create the slideshow with. You can open the finder window on mac for the images and videos and select the images you want to display. There are several ways to add slides to a presentation.
You can add a new slide,.
Now your desktop screen is casting to the tv. On your pc, open icloud for windows, click photos or photo stream, then click the options button. If my photo stream isn�t turned on, delete photos from the photos app instead. Delete photos on mac in one click. To remove unwanted markings, use the eraser tool, then click start erasing.







